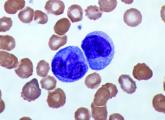

News

Elevated monocyte count predicts poor outcomes in idiopathic pulmonary fibrosis
Data indicate that a single threshold value of absolute monocyte counts of 0.95 K/mcL could be used to identify high-risk patients with a fibrotic...
Data indicate that a single threshold value of absolute monocyte counts of 0.95 K/mcL could be used to identify high-risk patients with a fibrotic...

SAN ANTONIO – Less that 1 second of light exposure over the course of 1 hour was enough to yield an effect.

The original approval was based on three phase 3, double blind, placebo-controlled trials, which demonstrated improvements in lung function and...

The health implications of cannabis vaping are unknown.

Study participants had suboptimal living conditions in lower income Philadelphia neighborhoods.

SAN ANTONIO – Experimental studies in mice have shown that disrupted sleep is associated with gut microbiota composition.

SAN ANTONIO – The explanation for lower CV risk in older patients with mild to moderate obstructive sleep apnea remains unclear.

SAN ANTONIO – The findings have implications for other eating paradigms, including time-restricted feeding.

Current screening recommendations to assess for children with Down syndrome for sleep disordered breathing may not be adequate.

Women with reduced sexual desire can experience marked distress or interpersonal difficulty.